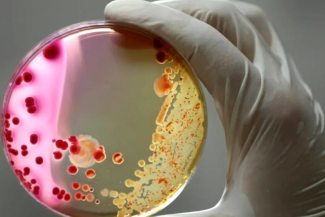

Fostul numărul 1 mondial Venus Williams s-a calificat, sâmbătă, alături de partenera sa Leylah Fernandez, în optimile de finală ale turneului de dublu feminin de la US Open.
Americanca în vârstă de 45 de ani şi partenera sa canadiană în vârstă de 22 de ani au învins cu 7-6 (7/1), 6-1 perechea formată din norvegianca Ulrikke Eikeri şi japoneza Eri Hozumi.
Pentru un loc în sferturile de finală, ele vor înfrunta fie perechea 100% britanică Sonay Kartal-Katie Boulter sau fie cuplul ruso-chinez Ekaterina Alexandrova-Zhang Shuai.
Revenită pe circuitul WTA la sfârşitul lunii iulie, la WTA 500 de la Washington, Venus Williams a fost eliminată în primul tur al US Open la simplu. Dar a primit în ultimul moment o invitaţie din partea organizatorilor pentru a participa la turneul de dublu .